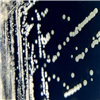

KCTC No. 19532
(KCTC Other No.)
Resource Type Bacteria
Name Streptomyces thermocarboxydus
Type Strain Yes
Biosafty Level 1
LMO No
Synonym
Phylum (ex Phylum) Actinomycetota (Actinobacteria)
Genome Information
History <- KS Bae, KRIBB
Source From earthworm Eisenia fetida, Korea
Other Collection No. RAG-19
Reference
KCTC Media No. KCTC media No. 493 R2A agar medium
Oxygen Requirement Aerobic
Temperature 25 ℃
pH netural pH ?? ?? (???? ??)
KCTC19532